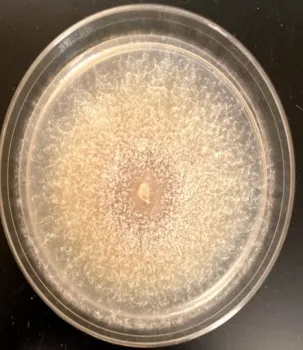
Raffaelea montetyi by Dr. Akif Eskalen, UC Davis
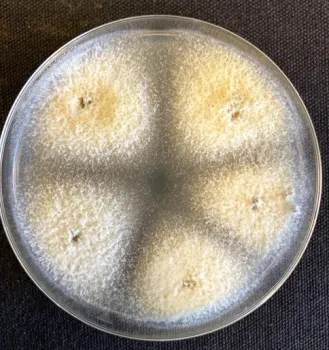
Fusarium solani by Dr. Akif Eskalen, UC Davis

All ambrosia beetles (like MOB) grow fungi inside their galleries and use it as food for larvae and adults. Some of these fungi can be pathogenic and cause tree diseases that may lead to tree decline and, sometimes, tree death.

Raffaelea montetyi, Fusarium solani, Paecilomyces formosus, Xenoacremonium recifei and at least seven additional unidentified fungi have been found in the MOB specimens in Napa County.

Work is ongoing to determine whether these fungi cause tree diseases. One of these, Raffaelea montetyi, has been shown to cause fatal wilt disease in cork oaks in Portugal.